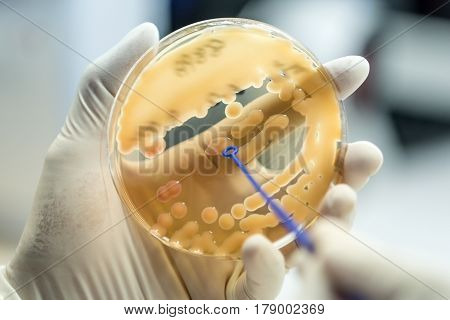
Klebsiella Pneumoniae Colonies Of Pink Bacteria Ferment Lactose Culture On Macconkey Agar In Microbi

Takarítson meg a Bigstock előfizetésekkel. Tudjon meg többet >
bezárás
Kép
Képek
klebsiella
stock fényképek
(Össztalálatszám: 710)